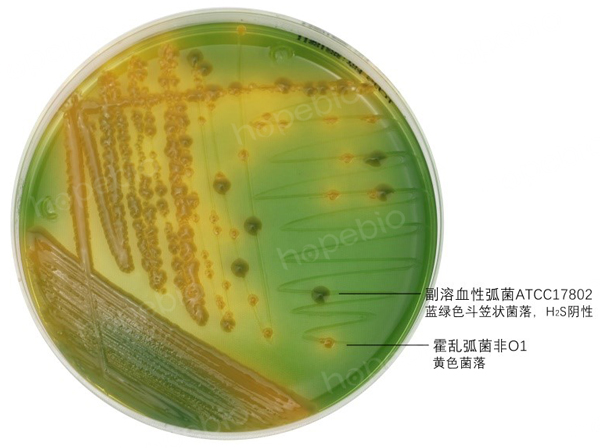
副溶血性弧菌在TCBS上生长特征

海博微信公众号
海博天猫旗舰店




副溶血性弧菌(Vibrio parahaemolyticus)为革兰氏阴性多形态杆菌或弯曲弧菌,(0.5~0.8) um×(1.4~2.6)um,无荚膜,无芽胞,有极生鞭毛(在液体培养基中形成一端单鞭毛,在固体培养基上可能出现周生鞭毛),具有嗜盐性,最适氯化钠浓度为35g/L,无盐培养基中不能生长。最适温度为37℃,最适pH为7.7~8.0,但pH 9.5时仍能生长。37℃培养18h-24h后,菌落呈圆形、微凸、光滑湿润、无色、半透明、边缘整齐,直径约2mm~3mm。致病性较强的菌株在含高盐甘露醇的兔血和人О型血的琼脂平板上产生β溶血(神奈川现象)。
副溶血性弧菌是一种常见的病原菌,主要栖息在海水中,存在于近海海水、海产品及盐渍食品中。如果食用了遭此菌大量污染的食品,会引发食物中毒。该菌是夏秋季节沿海地区食物中毒和急性腹泻的主要病原菌。
革兰氏镜检图
3%NaCl胰蛋白胨大豆琼脂培养基,36℃±1℃培养18h,菌体棒状、弧状、卵球状等多形态,革兰氏阴性,无荚膜,不产芽孢,有极生鞭毛。
TCBS
TCBS琼脂培养基,36℃±1℃培养24h,菌落蓝绿色斗笠状、硫化氢阴性,用接种环接触,有类似口香糖的质感。
弧菌显色培养基
弧菌显色培养基,36℃±1℃培养24h,菌落为蓝绿色、圆形、表面光滑。
生化
嗜盐性试验
无盐胰胨水:阴性;6%氯化钠胰胨水:阳性;
8%氯化钠胰胨水:阳性;10%氯化钠胰胨水:阴性。
三糖铁穿刺
三糖铁斜面产碱变红,底层产酸变黄,不产硫化氢,不产气。
神奈川实验
致病性较强的副溶血性弧菌在我妻氏琼脂平板上产生β溶血环。
相关产品
上一篇:微生物的营养物质
下一篇:微生物培养基的配制原则
